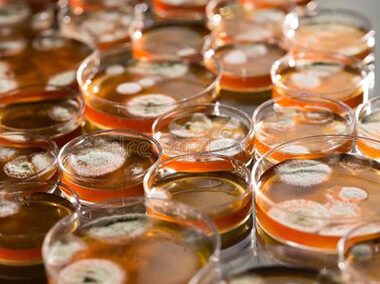

About Us
About Springchem
Suzhou Springchem International Co., Ltd. has been specializing in the research and development and production of daily chemical fungicides and other fine chemicals since 1990s. Our factory located in Zhejiang province. We have our own production base of daily chemical and bactericide and is a national high-tech enterprise with municipal R&D engineering center and pilot test base.We had awarded as“The best cost-control supplier”by key account. Our products has sold in domestic and abroad, some of our product series has good cooperation with many famous enterprises in China. We supply more than the finest, high-performance chemical raw materials , we provide expertise that is culminated over years of research and development in the production, supply and application . We produce a wide range of products that can be used in personal care and cosmetic industry,like skin care, hair care, oral care, cosmetics,household cleaning,detergent and laundry care,hospital and public institutional cleaning.
Environmental Impact Assessment (EIA)
We have obtained complete production formalities. All the production and operation are legal and reliable.
We got all approvals of Work Safety:Safety Production License and Certificate of Work Safety Standardization.
We got the Environmental Protection Approval: Pollution-Discharge Permit of Zhejiang Province.
Quality Control And Challenging Test
We established our reputation upon the belief that consistency in quality is essential.
In our own Q.C laboratories we have a complete set of microbial control programs.
The antisepsis experiment was carried out by simulating the actual situation.
The microbial analysis of bad products is also available.
Honor Certificate
We was awarded as high-tech enterprise of Zhejiang province we were ranked by National Credit Evaluation Center and National Investigative Statistic Trade Association as Grade AAA Trust Enterprise in Chinese Building Material Trade.we pass High-tech SME technology innovation Fund Project, Which greatly promote the company to a fast development.
ISO14001
OHSMS18001
ISO9001
Historical Process
Future spring group will constant brand upgrading, marketing and services.